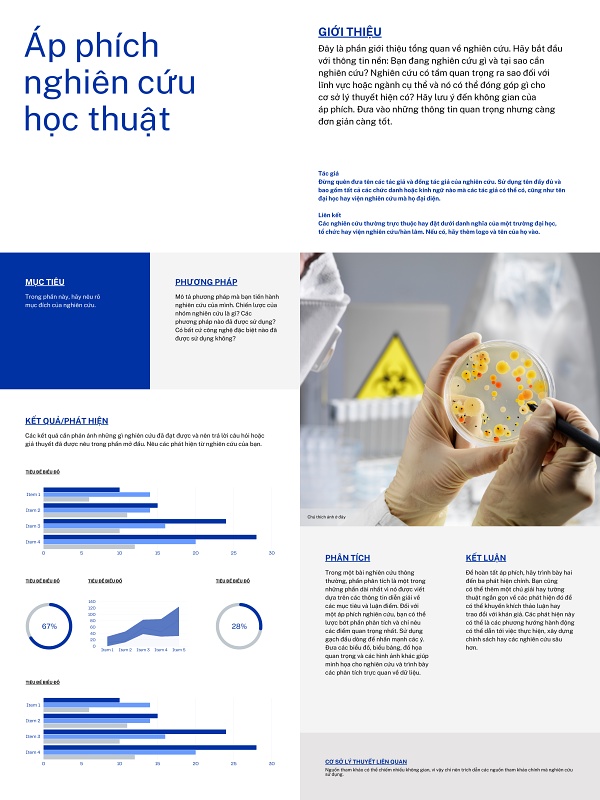

Mục lục bài viết
Sinh viên và các nhà nghiên cứu thường gặp khó khăn khi trình bày poster báo cáo nghiên cứu khoa học do bố cục quá rối rắm, cỡ chữ quá nhỏ hoặc hình ảnh minh họa bị vỡ nét khi in khổ lớn. Một poster báo cáo nghiên cứu khoa học thiếu tính thẩm mỹ và khoa học có thể làm giảm giá trị của công trình nghiên cứu trong mắt ban giám khảo.
Ở bài viết này, In Viva cung cấp trọn bộ mẫu poster báo cáo nghiên cứu khoa học chuẩn vector sắc nét, giúp bạn dễ dàng tùy chỉnh nội dung và sơ đồ để có một bản báo cáo ấn tượng, chuyên nghiệp.
Tham khảo 10+ mẫu poster báo cáo nghiên cứu khoa học chuyên nghiệp
Poster báo cáo khoa học cần sự cân bằng giữa nội dung và tính trực quan. Các mẫu thiết kế thường sử dụng bố cục cột rõ ràng, màu sắc trung tính và font chữ dễ đọc để giúp người xem tiếp cận thông tin nhanh chóng. Tham khảo các mẫu dưới đây sẽ giúp bạn định hình cách trình bày chuyên nghiệp, phù hợp cho hội nghị và học thuật.

Tải 15+ mẫu poster báo cáo nghiên cứu khoa học
Để hỗ trợ tốt cho công việc nghiên cứu và học tập, Xưởng In Viva đã tổng hợp các mẫu poster sắc nét với đầy đủ định dạng phổ biến.
| Loại định dạng | Thế mạnh kỹ thuật | Mục đích sử dụng |
|---|---|---|
| Vector (AI, EPS) | Không vỡ nét khi phóng to, tùy chỉnh sơ đồ linh hoạt. | In ấn poster khổ lớn dán bảng tin, triển lãm khoa học. |
| Powerpoint (PPTX) | Dễ sử dụng cho người không chuyên về đồ họa. | Thuyết trình trực tiếp hoặc in nhanh tại văn phòng. |
| PNG High Res | Hình ảnh minh họa sắc nét, độ phân giải 300dpi. | Chèn vào báo cáo tổng kết, đăng website viện nghiên cứu. |
| Giữ nguyên bố cục và font chữ trên mọi thiết bị. | Gửi file trực tiếp cho đơn vị in ấn để giữ độ chuẩn xác. |
Việc sở hữu file vector chuẩn giúp bạn hoàn toàn yên tâm về chất lượng khi in ấn. Mọi chi tiết từ các ký hiệu toán học đến các biểu đồ phức tạp đều được thể hiện rõ ràng, chuyên nghiệp.
05 sai lầm cần tránh khi thiết kế poster nghiên cứu khoa học
Để bản báo cáo của bạn được đánh giá cao, hãy lưu ý tránh các lỗi phổ biến sau đây:
- Sử dụng quá nhiều văn bản: Poster báo cáo nghiên cứu khoa học không phải là bài báo khoa học đầy đủ. Sai lầm là copy toàn bộ nội dung văn bản vào poster khiến chữ bị quá nhỏ. Hãy sử dụng các gạch đầu dòng và để hình ảnh, biểu đồ nói thay thông điệp của bạn.
- Độ phân giải biểu đồ thấp: Việc chụp màn hình biểu đồ rồi kéo dãn trên poster sẽ làm các con số bị mờ nhòe. Điều này cực kỳ tối kỵ trong báo cáo khoa học. Hãy luôn xuất biểu đồ từ phần mềm gốc ở định dạng vector hoặc ảnh chất lượng cao.
- Lỗi font chữ ký hiệu chuyên ngành: Các công thức hóa học hoặc toán học thường bị lỗi font khi mở trên các máy tính khác nhau. Bạn nên chuyển các nội dung này sang dạng hình ảnh vector (Outline) để các ký hiệu không bị nhảy sang ký tự lạ khi in ấn.
- Bố cục lộn xộn, thiếu logic: Người xem thường đọc poster từ trái sang phải và từ trên xuống dưới. Nếu bạn sắp xếp các mục không theo trình tự này, người xem sẽ rất khó nắm bắt được mạch nghiên cứu của bạn. Hãy sử dụng các con số đánh thứ tự nếu cần thiết.
- Phối màu quá sặc sỡ: Một poster khoa học cần sự nghiêm túc. Việc sử dụng quá nhiều màu sắc rực rỡ không chỉ làm rối mắt mà còn làm giảm tính chuyên nghiệp của người làm nghiên cứu. Hãy giới hạn trong khoảng 2-3 màu chủ đạo thống nhất cho toàn bộ poster.
Sản xuất quà tặng in logo cho viện nghiên cứu và trường đại học
Xưởng In Viva là đơn vị chuyên nghiệp trong việc cung cấp các giải pháp quà tặng in logo công ty cho các đơn vị giáo dục, viện nghiên cứu và doanh nghiệp khoa học. Chúng tôi hiểu rằng mỗi món quà tặng như sổ tay, bút ký, bình giữ nhiệt hay bộ ấm chén gốm sứ đều mang giá trị tinh thần và thương hiệu rất lớn.
Với diện tích xưởng 2.000m2 và đội ngũ 50 nhân viên giàu kinh nghiệm, chúng tôi cam kết đáp ứng mọi nhu cầu in ấn logo quà tặng một cách sắc nét. Chúng tôi áp dụng các công nghệ hiện đại như in UV, khắc laser, in nung men sứ đảm bảo logo thương hiệu luôn bền màu và sang trọng.
In Viva chủ động trong mọi khâu từ thiết kế mockup miễn phí đến sản xuất trực tiếp không qua trung gian, giúp khách hàng nhận được báo giá minh bạch và cạnh tranh. Khả năng sản xuất của xưởng đạt 10.000 sản phẩm/ngày, cam kết đúng tiến độ từ 5 – 10 ngày làm việc.
Bên cạnh đó, In Viva còn chuyên sản xuất bao bì hộp giấy, túi giấy cao cấp để đựng quà tặng cho các hội thảo khoa học, sự kiện vinh danh. Với quy trình làm việc chuyên nghiệp và chính sách bảo hành, đổi trả minh bạch, chúng tôi tự hào là đối tác của nhiều trường đại học lớn tại Việt Nam. Dịch vụ giao hàng miễn phí nội thành là một điểm cộng giúp khách hàng tiết kiệm thời gian và chi phí vận chuyển.
FAQs – Câu hỏi thường gặp
1. Tôi có thể thay đổi kích thước mẫu poster khoa học tải về không?
Có, với định dạng vector AI hoặc EPS, bạn có thể dễ dàng thay đổi kích thước từ A4 lên A0 mà không lo bị vỡ nét.
2. File Powerpoint có bị lỗi font khi gửi đi in không?
Để an toàn, bạn nên xuất file Powerpoint sang định dạng PDF hoặc gửi kèm bộ font chữ để nội dung không bị nhảy font khi in.
3. In Viva có nhận in logo lên sổ tay làm quà tặng sinh viên nghiên cứu không?
Có, In Viva chuyên in logo lên sổ tay, bút ký bằng công nghệ in UV hoặc ép kim, giúp món quà trở nên sang trọng và ý nghĩa.
Liên hệ hotline: 0971.729.499 để nhân viên In Viva tư vấn in logo thương hiệu lên quà tặng và nhận báo giá tốt trên thị trường nhé!

Trang Chủ
LĨNH VỰC
Standee
Name Card
Túi Giấy
Hộp Cứng
In decal
Bao thư
Ưu đãi